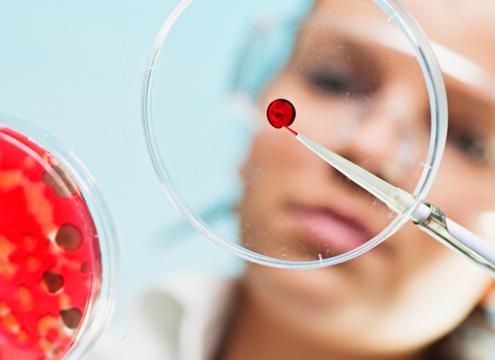

Hochwertiges Textilrecycling durch Einbindung bestehender Expertise
Mit der Novellierung der Abfallrahmenrichtlinie wird die Grundlage…

Schrottmarkt kompakt: Leichte Stabilisierung – aber die Unsicherheiten bleiben
Im Berichtsmonat November zeigte sich der Stahlschrottmarkt weiterhin…

VDI-Richtlinie: Asbest in mineralischen Bau- und Abbruchabfällen
Asbesthaltige Baustoffe finden sich in vielen Gebäuden, die…

Schwer verwertbare Papierfasern wieder nutzbar machen
Getränkepappbecher, Verpackungspapiere oder Tapeten gehören…

Recyclingfähige Leichtbauteile aus Holz senken CO₂-Emissionen
Im Projekt „HyEnd-Wood“ wurden holzbasierte Verbundwerkstoffe…
Bio-Recycling von Kunststoff: Mikroben machen aus Plastik neue Wertstoffe
Es gibt verschiedene Methoden, gebrauchtes Plastik sinnvoll zu…

Lithium-Rückgewinnung kommt großen Schritt voran
In Krefeld wurde eine Anlage im industrienahen Maßstab installiert,…

Schrottmarktbericht Dezember 2025: Lustloser Markt bei mäßiger Verkaufsbereitschaft
Deutschland bleibt trotz Wirtschaftskrise größter Nettozahler…

Neugerätemenge wächst schneller als die Sammlung von Elektroschrott
Im Jahr 2023 wurden in der EU pro Einwohner offiziell 11,6 Kilogramm…

Trimet entwickelt Recyclingvariante zur Druckgusslegierung
Die Trimet Aluminium SE arbeitet an der Weiterentwicklung der…
